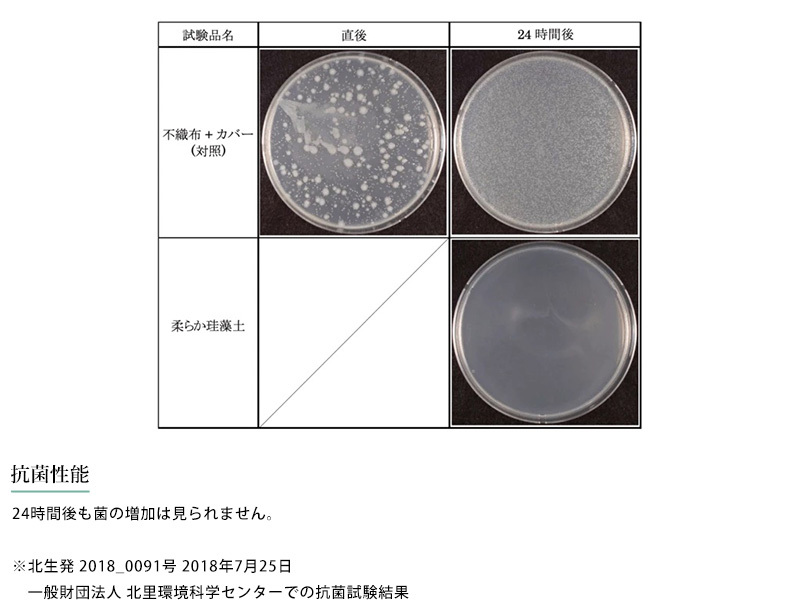

| ■スタッフのおすすめポイント■ |
快適で清潔な足元をキープ 珪藻土フットクッション 柔らか珪藻土テクノロジーを活用し、高い通気性・消臭・抗菌機能を兼ね備えたフットクッション。粉末状の内部構造なので長時間座っていても通気構造がつぶれることがなく、快適な状態が続きます。消臭・抗菌性能も備えているので、衛生的にお使いいただくことが可能です。 |

| ■送料について |
| こちらの商品は、送料無料でお届けします。 ※こちらの商品は複数個お買い上げいただいた場合でも、1個分の送料でお届けします。 (送料が異なる場合には高いものに設定されます。) ※複数のアイテムを同時にご注文いただきました場合には、 商品が全て揃ってからの出荷となります。 ※出荷時期が異なる商品や納期が遅れる商品がございます場合にも、 商品の入荷確認後の出荷となります。 |